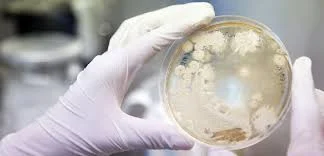
René Dubos

-
 Propuso que la fermentación se debía a la acción de microorganismos específicos.
Propuso que la fermentación se debía a la acción de microorganismos específicos.
Aplicación: en la industria alimentaria (vino, cerveza, pan, lácteos). -
 Louis Pasteur desarrollo del proceso de pasteurización para la conservación de alimentos y bebidas al reducir microorganismos patógenos.
Louis Pasteur desarrollo del proceso de pasteurización para la conservación de alimentos y bebidas al reducir microorganismos patógenos. -
 Identificó el Bacillus anthracis como agente causal del ántrax, creando el primer vínculo práctico entre microorganismo y enfermedad animal (veterinaria aplicada).
Identificó el Bacillus anthracis como agente causal del ántrax, creando el primer vínculo práctico entre microorganismo y enfermedad animal (veterinaria aplicada). -
 Robert Koch realizó el descubrimiento y diagnóstico para el control de la tuberculosis en salud pública.
Robert Koch realizó el descubrimiento y diagnóstico para el control de la tuberculosis en salud pública. -
 Louis Pasteur: Medicina preventiva: vacunación humana y veterinaria.
Louis Pasteur: Medicina preventiva: vacunación humana y veterinaria. -
 Descubrimiento de la antitoxina diftérica.
Descubrimiento de la antitoxina diftérica. -
 Desarrollo del Salvarsán (arsfenamina), primer quimioterápico contra la sífilis
Desarrollo del Salvarsán (arsfenamina), primer quimioterápico contra la sífilis -
 Descubrimiento de la penicilina
Descubrimiento de la penicilina -
 Descubrimiento de la estreptomicina.
Descubrimiento de la estreptomicina. -
Desarrollo de antibióticos derivados de actinobacterias del suelo.
Desarrollo de antibióticos derivados de actinobacterias del suelo. -
 Producción de insulina humana recombinante en E. coli.
Producción de insulina humana recombinante en E. coli. -
 Desarrollo de la reacción en cadena de la polimerasa (PCR).
Desarrollo de la reacción en cadena de la polimerasa (PCR). -
 Secuenciación completa del genoma de Haemophilus influenzae.
Secuenciación completa del genoma de Haemophilus influenzae. -
 Desarrollo del sistema CRISPR-Cas9 como herramienta de edición genética.
Desarrollo del sistema CRISPR-Cas9 como herramienta de edición genética. -
Madigan, M. T., Bender, K. S., Buckley, D. H., Sattley, W. M., Stahl, D. A. (2018). Brock Biology of Microorganisms (15th ed.). Pearson. Tortora, G. J., Funke, B. R., Case, C. L. (2020). Microbiología (13.ª ed.). Pearson Educación. Ryan, K. J., Ray, C. (2022). Sherris Medical Microbiology (8th ed.). McGraw Hill. Dubos, R. (1950). The Bacterial Cell. Harvard University Press. Venter, J. C. (1995). The sequence of the Haemophilus influenzae genome. Science, 269(5223), 496–512
Want to make a timeline like this?
Use Timetoast to turn dates, events, milestones, and phases into a clear visual timeline you can build and share. Timetoast is a timeline maker for work, school, research, and stories.